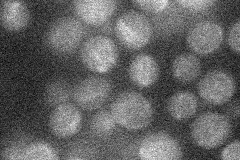
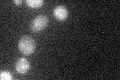

View description
Meiosis-specific subunit of the t-SNARE complex, required for prospore membrane formation during sporulation; similar to but not functionally redundant with Sec9p; SNAP-25 homolog
Localization:
Intensity:
Fold change:
Significance:
-
C’ GFP library in SD

below threshold15.41 -
N' NOP1pr-GFP in SD
punctate13.6617 -
N' TEF2pr-mCherry in SD

below threshold4.85138 -
N' NATIVEpr-GFP in SD

below threshold17.1021 -
N' TEF2pr-VC and Cyto-VN in SD

#N/A0 -
C’ GFP library in SD+DTT

cytosol16.111.04No -
C’ GFP library in SD+H2O2

cytosol17.261.12No -
C’ GFP library in Starvation Media
cytosol25.261.63No -
C’ GFP library on the background of Pup2-DaMP

below threshold -
C’ GFP library on the background of CCT mutant

below threshold16.51021.07109No
